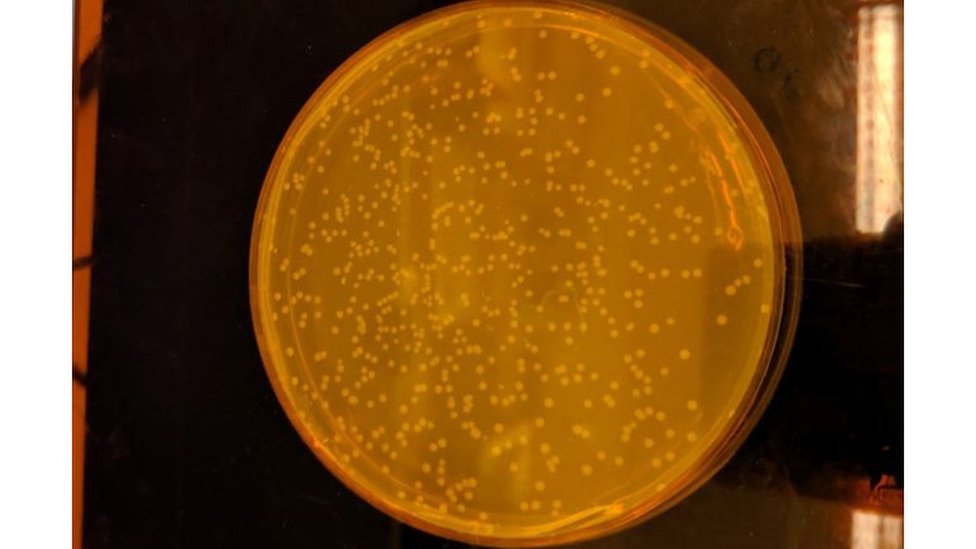
Image

17 de mayo de 2019 - 17:22h
Cómo es el primer organismo vivo del mundo creado por científicos con un código ADN completamente sintético
2 de mayo de 2016 - 18:13h
Gran avance científico para tratar con mayor eficacia cáncer de mama
28 de marzo de 2016 - 10:14h
Crean en EE.UU. una célula que amplía la posibilidad de vida sintética
1 de noviembre de 2015 - 10:04h

